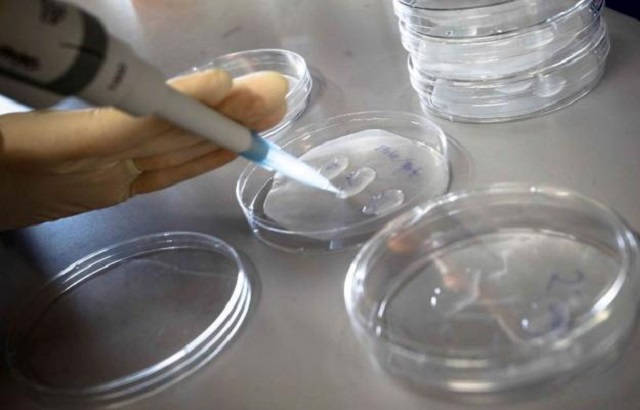

Investigadores del Instituto de Investigación de Barcelona (IRB) de Barcelona y del CSIC han descubierto que la suma de dos señales moleculares determina qué células ya especializadas de un tejido puedan volver a actuar como células madre.
El estudio, que publica la revista Plos Genétic, ha sido efectuado con moscas del vinagre y, según el IRB, permiten avanzar en un campo de interés para la medicina regenerativa y para entender procesos como el cáncer.
Los científicos del IRB y del CSIC (Consejo Superior de Investigaciones Científicas) Nareg J. Djabrayan y Jordi Casanova han identificado dos señales moleculares y la cascada correspondiente de eventos que permiten a unas células ya especializadas de un tejido volver a actuar como células madre.
El trabajo ofrece nuevos datos sobre cómo se especifican y cómo se activan “ese otro tipo” de células madre, llamadas facultativas, y que son de interés en la reprogramación celular, la medicina regenerativa y para entender el cáncer.
“La existencia de las facultativas indica que muchas células diferenciadas continúan teniendo una gran plasticidad y son capaces de responder en una situación de estrés, ya sea cuando se produce una herida o para regenerar un tejido desgastado, tal y como lo hacen las células madre”, explicó el jefe del grupo Desarrollo y morfogénesis en Drosophila del IRB, Jordi Casanova.
“Esta plasticidad es buena si está bien regulada. Si cualquiera de los mecanismos se desequilibra se vuelve peligroso. De hecho, la plasticidad celular en tejidos que requieren una alta regeneración se correlaciona con algunos de aquellos órganos y tejidos con alta incidencia de cánceres, como el colon o la sangre”, señaló el científico.
Los investigadores han trabajado en el momento de transición de una larva de Drosophila a mosca adulta.
“El nuestro es un buen modelo para identificar y estudiar las células madre facultativas porque hay unas células de la larva que darán lugar al adulto y que se activan en el paso de larva a adulto, transición que puede considerarse similar a un momento de estrés”, según Casanova.
En concreto, los científicos han estudiado estas células con características de células madre facultativas en las tráqueas de Drosophila y han determinado que sólo algunas células del tejido reciben una señal de localización que las “marca”.
Luego, cuando hay una situación de transición, envían una segunda señal, promovida por hormonas, que motiva la reactivación del programa de célula madre.
Esta señal llega a todas las células del tejido pero solo las marcadas con la señal geográfica previa, podrán reactivarse como célula madre.
“Conocer todos estos mecanismos de señales de regulación es básico para poder controlar, por ejemplo, la reprogramación de células”, indicó Casanova.
Con el mismo modelo, los científicos quieren averiguar ahora los mecanismos que permiten a las células diferenciadas mantener la plasticidad y cómo pueden pasar de un programa de célula especializada a célula madre y viceversa.